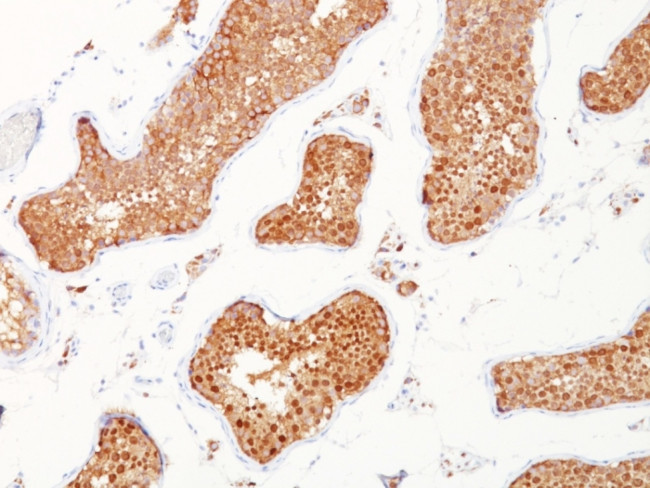
Inhibin, alpha (INHA) (Gonadal Cell Marker) Antibody in Immunohistochemistry (Paraffin) (IHC (P))

Search
NeoBiotechnologies
Inhibin, alpha (INHA) (Gonadal Cell Marker) Monoclonal Antibody (INHA/1168)
{{$productOrderCtrl.translations['antibody.pdp.commerceCard.promotion.promotions']}}
{{$productOrderCtrl.translations['antibody.pdp.commerceCard.promotion.viewpromo']}}
{{$productOrderCtrl.translations['antibody.pdp.commerceCard.promotion.promocode']}}: {{promo.promoCode}} {{promo.promoTitle}} {{promo.promoDescription}}. {{$productOrderCtrl.translations['antibody.pdp.commerceCard.promotion.learnmore']}}
产品信息
3623-MSM1-P0
种属反应
宿主/亚型
分类
类型
克隆号
抗原
偶联物
形式
浓度
规格
纯化类型
保存液
内含物
保存条件
运输条件
靶标信息
The inhibin alpha subunit joins either the beta A or beta B subunit to form a pituitary FSH secretion inhibitor. Inhibin has been shown to regulate gonadal stromal cell proliferation negatively and to have tumor-suppressor activity. In addition, serum levels of inhibin have been shown to reflect the size of granulosa-cell tumors and can therefore be used as a marker for primary as well as recurrent disease. However, in prostate cancer, expression of the inhibin alpha-subunit gene was suppressed and was not detectable in poorly differentiated tumor cells. Furthermore, because expression in gonadal and various extragonadal tissues may vary severalfold in a tissue-specific fashion, it is proposed that inhibin may be both a growth/differentiation factor and a hormone.
仅用于科研。不用于诊断过程。未经明确授权不得转售。
篇参考文献 (0)
生物信息学
蛋白别名: A inhibin subunit; A-inhibin subunit; IHA; inhibin; inhibin A; inhibin A-subunit precursor; Inhibin alpha chain; inhibin alpha subunit
基因别名: INHA
UniProt ID: (Human) P05111
Entrez Gene ID: (Human) 3623